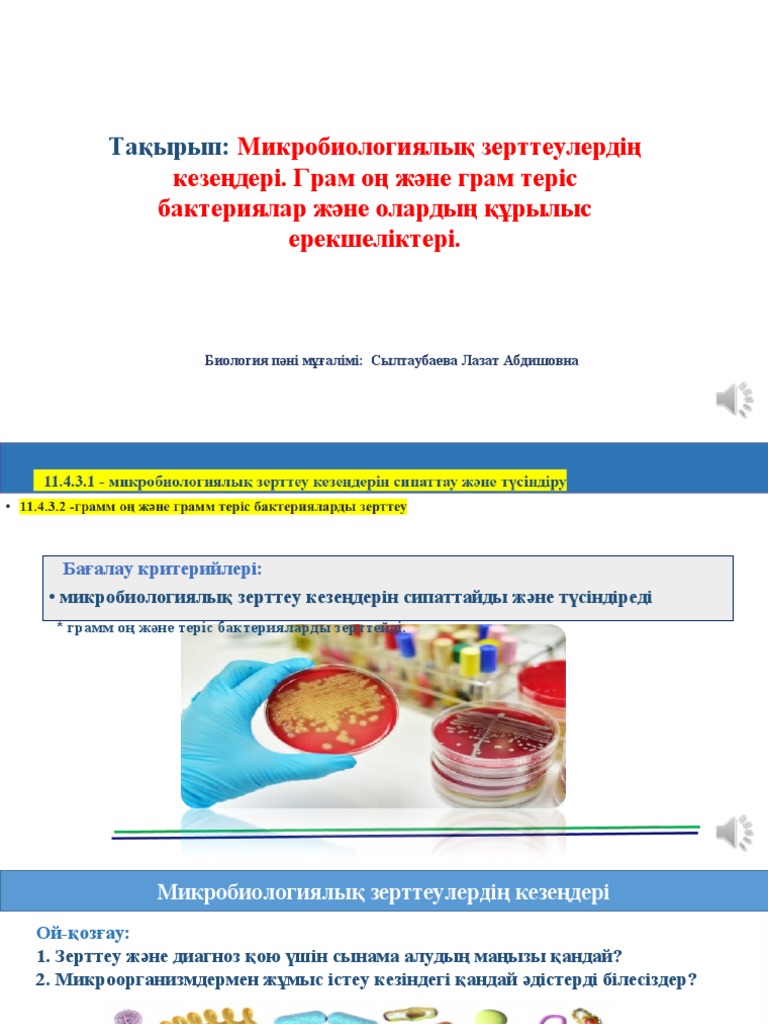
Жағажайдағы микробикинидегі әйелдердің фотосуреттері

Жағажайдағы микробикинидегі әйелдердің фотосуреттері
Секс пен интимдік мәдениет психологиялық білім мен тәжірибенің пайда болуына белгісіз сексуалдық тәжірибе туралы сұраныс.








Секс пен интимдік мәдениет психологиялық білім мен тәжірибенің пайда болуына белгісіз сексуалдық тәжірибе туралы сұраныс.